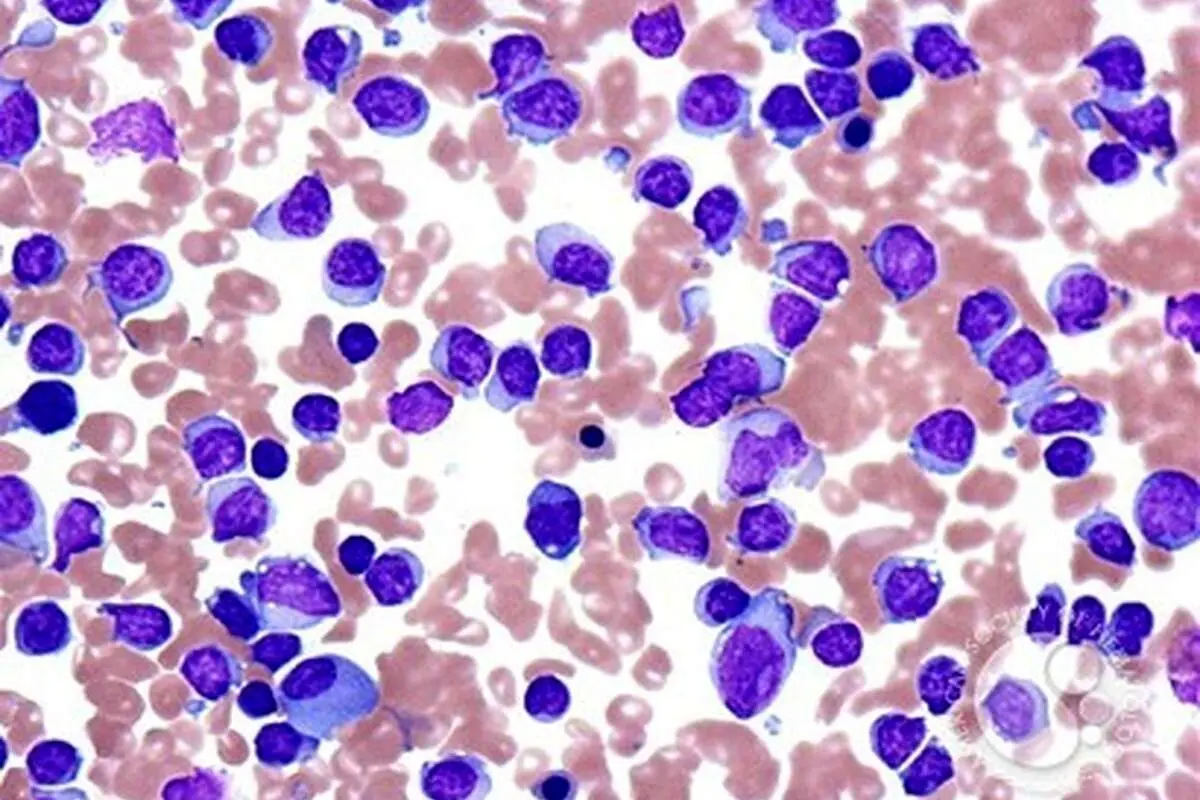
لوسمی لنفوسیتی یا سرطان خون چیست؟

لوسمی لنفوسیتی یا سرطان خون چیست؟
لوسمی لنفوسیتی نوعی سرطان است که لنفوسیتها را مورد حمله قرار میدهند. لنفوسیتها نوعی گلبول سفید هستند که به بدن برای مقابله با عفونتها کمک میکند.
به گزارش فرارو، معمولا بسیاری از بزرگسالان به لوسمی CLL دچار میشوند، بیماریای که به آرامی پیشرفت میکند و ممکن است برای سالها علائم و نشانه آشکاری از بیماری را نداشته باشد. افراد بزرگسال بیشتر از سایر انواع لوسمی دچار لوسمی لنفوسیتی مزمن میشوند. در بسیاری از مواقع این لوسمی هیچ علامتی ندارد و تنها کسی متوجه آن میشود که برای آزمایش خون معمولی به پزشک مراجعه کرده باشد و موردی مشکوک در آن دیده شود.
علائم لوسمی لنفوسیتی مزمن
• ورم غدد لنفاوی در گردن، زیر بغلها یا ران
• کاهش وزن بدون هیچ دلیلی
• خستگی شدید
• تب یا دمای بالا، اغلب به علت عفونت
• تعریق شبانه
• کاهش اشتها
• تنگی نفس
• درد یا احساس سیری در معده که ممکن است به علت بیماری ایجاد شده از بزرگی طحال باشد
تشخیص
• آیا اخیرا عفونت داشتهاید؟
• اخیرا صدمه یا تصادف داشتهاید؟
• آیا بیماریهای سیستم ایمنی دارید؟
• تب دارید؟
• تنگی نفس دارید؟
• اخیرا بدون تلاش برای کم کردن وزن، کاهش وزن داشتهاید؟
• چه داروهایی مصرف میکنید؟
• تست استنشاقی: پزشک یک سوزن نازک را داخل مغز استخوان (معمولا از طریق ران) خواهد کرد تا مقدار کمی از مغز استخوان مایع را بر دارد.
• نمونهبرداری: پزشک با استفاده از یک سوزن کمی بزرگ مقدار کمی استخوان، مغز استخوان و خون را برای بررسی بر میدارد.
پزشک با بررسی نمونهها زیر میکروسکوپ برای سلولهای غیر طبیعی به فرد میگوید که آیا لوسمی لنفوسیتی مزمن دارد و با چه سرعتی در حال پیشرفت است. این نمونهها نکاتی هم در مورد تغییرات ژنتیکی در سلولها بیان خواهند کرد. این اطلاعات ممکن است به پزشک برای برنامهریزی مناسب درمانی کمک کند.
سوالاتی که از پزشک باید بپرسید
• آیا هماکنون نیاز به درمان است؟
• چه موقع نیاز به درمان خواهد بود؟
• آیا قبل از تصمیمگیری نیاز به انجام تستهای دیگر است؟
• چه زمانی نظر نهایی انجام میشود؟
• عوارض جانبی درمان چیست؟
• آیا روی زندگی روزمره اثر خواهد گذاشت؟
• در صورت بازگشت دوباره لوسمی چه کار باید کرد؟
درمان
• شیمی درمانی: اینها داروهایی هستند که سلولهای سرطانی را از بین میبرند یا کنترل میکنند. پزشکان معمولا دو یا چند دارو را ترکیب میکنند که به روش متفاوتی عمل میکنند. شیمی درمانی ممکن است با قرص، آمپول یا تزریقهای وریدی انجام شود. داروها از طریق خون به سایر نقاط بدن منتقل میشوند تا به سلولها برسند و روی آنهایی که بهسرعت در کل بدن تقسیم میشوند، تاثیر بگذارند. این کار علاوهبر سلولهای سرطانی شامل سلولهای سالم خاصی نیز میشود.
معمولا بیماران باید شیمی درمانی را در یک چرخه ۳ تا ۴ هفتهای انجام بدهند که شامل یک زمان درمان و یک زمان بدون درمان است. این زمان استراحت زمانی برای بازسازی و بهبود به سلولهای بدن است. عوارض جانبی میتواند شامل زخم دهان، تهوع و پایین بودن تعداد گلبولهای خون باشد، البته پس از آن دوره بهبود پیدا میکنید. تقریبا تمام عوارض جانبی پس از اتمام درمان به مرور از بین خواهند رفت. عوارض جانبی را میتوان درمان کرد یا حتی از بروز برخی از آنها پیشگیری کرد.
• ایمونوتراپی: این داروها از پروتئین سیستم ایمنی بدن انسان ساخته میشوند که به سیستم ایمنی بدن کمک میکنند تا سلولهای سرطانی را شناسایی و تخریب کند. (پزشکان معمولا آن را آنتی بادیهای مونوکلونال مینامند). آنها به پروتئینهای مشخصی متصل میشوند که سلولهای سرطانی را میسازند. بیمار آنها را از طریق تزریق وریدی یا آمپول دریافت میکند. پزشک این درمان را ممکن است به تنهایی انجام بدهد؛ اما بسیاری از بیماران آن را همراه با شیمی درمانی دریافت خواهند کرد.
داروهای ایمونوتراپی عوارض متفاوتی نسبت به داروهای شیمی درمانی دارند. سر درد، تب، جوش و تغییرات فشار خون تنها چند مورد از عوارض این شیوه درمانی هستند. از بروز برخی از عوارض میتوان پیشگیری و همه را درمان کرد.
• درمان هدفمند: این داروها پروتئینهای خاصی را داخل و روی سلولهای سرطانی مسدود میکنند؛ همچنین به آنها برای بقا و انتشار کمک فراوانی میکنند. درحقیقت پروتئینهای موجود در سلولهای لوسمی لنفوسیتی مزمن C.L.L و سلولهای سالم ضعیف را هدف میگیرند. این داروها به شکل قرص مصرف میشوند.
عوارض جانبی به مسئلهای بستگی دارد که در درمان هدفگذاری شده مورد استفاده قرار میگیرد. عوارض ممکن است شامل تعداد پایین گلبولهای خون، اسهال، استفراغ، خستگی و جوشهای پوستی باشد. این مسائل را میتوان و باید درمان کرد. بسیاری پس از درمان این علائم بهبود مییابند.
یکی از روشهای درمانی که ممکن است احتمال کمی برای انجام آن وجود دارد، عبارتاند از:
• پرتو درمانی: این نوع از درمان با استفاده از اشعههایی با انرژی بالا همانند اشعه ایکس برای از بین بردن سلولهای سرطانی انجام میشود. از این روش همچنین میتوان برای کوچک کردن غده لنفاوی متورم، طحال یا برای درمان درد استخوان استفاده کرد.
• جراحی: استفاده از این روش بسیار نادر است، در صورتی که شیمی درمانی یا پرتو درمانی طحال بزرگ شده را کوچک نکند، ممکن است از جراحی برای انجام این کار استفاده کرد. این روش به افزایش و تنظیم تعداد گلبولهای خون کمک مفیدی میکند.
• لوکوفرزیس: در صورتی که تعداد زیادی از سلولهای CLL به هنگام تشخیص در خون بیمار وجود داشته باشد، این احتمال وجود دارد که پزشک از این درمان برای کاهش سریعتر آنها استفاده کنید. خون از یک دستگاه خاص که سلولهای CLL را به سمت بیرون فیلتر میکند، عبور میکند. این یک ترمیم و درمان کوتاه مدت است و برای درمان و کنترل سلولهای سرطانی بیمار نیازمند درمان دیگری همانند شیمی درمانی یا ایمونوتراپی است.
• آزمایشات بالینی: گزینههای درمانی دیگری را پیشنهاد میکنند. اینها مطالعاتی هستند که دانشمندان از آنها برای یافتن روشهایی بهتر برای درمان بیماریها استفاده میکنند. آنها ممکن است روشی برای انجام درمانهای جدید ارائه بدهند، قبل از آنکه برای همگان قابل استفاده باشند. بیمار حداقل یکی از بهترین درمانهای موجود را در آزمایشات بالینی دریافت خواهد کرد؛ اما ممکن است درمانهایی هم روی آنها انجام شود که پزشکان تصور میکنند برای درمان CLL امیدبخش و موثر است. پزشک میتواند برای یافتن آزمایشات بالینی در حال انجام و آنچه که آن را شامل میشود، کمک کند؛ بنابراین تصمیم درنهایت با خود بیمار است که کدام درمان را امتحان کند.
• پیوند سلولهای بنیادی: پژوهشگران درحال تحقیق در مورد ترکیبات جدید و موجود داروها و روشهای جدید درمان لوسمی لنفوسیتی مزمن برای کمک به بیماران هستند تا مدت زمان بیشتری را بدون بیماری سپری کنند. یکی از این درمانها ترکیبی از شیمی درمانی با پیوند سلولهای بنیادی است. بسیاری از بیماران CLL نیازی به این روش برای درمان ندارند.
شیمی درمانی سلولهای سرطانی را از بین میبرد؛ همچنین به تعدادی از سلولهای سالم در مغز استخوان نیز آسیب میرساند. پیوند سلولهای بنیادی به سلولهای جوان سالم کمک میکند تا سیستم ایمنی را بازسازی کنند. اینها سلولهای بنیادی "جنینی" نیستند که ممکن است در مورد آنها شنیده باشید. آنها معمولا از مغز استخوان یک اهدا کننده به دست میآیند.
افراد با بستگان نزدیک همانند برادر یا خواهر بهترین شانس برای پیوند مغز استخوان را دارند. در صورتی که آنها مناسب نباشند، باید به لیست اهدا کنندگان (بانک اهدا کنندگان سلولهای بنیادی) غریبه مراجعه شود. برخی مواقع بهترین شانس برای یافتن سلولهای بنیادی مناسب برای بیمار این است که اهدا کننده از همان نژاد یا پیشینه رفتاری فرد برخوردار باشد.
قبل از اهدا احتمالا دوزهای بالایی از داروهای شیمی درمانی برای حدود یک هفته تا دو هفته به فرد داده شود. این کار میتواند روندی دشوار باشد؛ زیرا ممکن است عوارض جانبی مانند تهوع و زخم دهان را ایجاد کند.
هنگامی که دوز بالایی از شیمی درمانی انجام شود، پیوند آغاز خواهد شد. فرد سلولهای بنیادی جدید را با یک تزریق وریدی دریافت خواهد کرد. هیچ احساس ناخوشایندی را تجربه نخواهد کرد و فرد حین انجام آن فرد کاملا بیدار خواهد بود.
پس از پیوند ۲ تا ۶ هفته طول میکشد تا سلولهای بنیادی تکثیر شوند و شروع به ساختن سلولهای جدید کنند. در طول این مدت فرد باید در بیمارستان بستری باشد یا حداقل باید به صورت مداوم و مرتب به بیمارستان مراجعه کند تا تیم پیوند شرایط او را بررسی کنند. این کار میتواند ۶ ماه تا یک سال زمان ببرد تا تعداد سلولهای خون طبیعی شوند و به وضعیتی بازگردند که باید باشند.
• از پزشک خود در مورد داروهای ضد تهوع سوال کنید. ماساژ درمانی و طب سوزنی نیز ممکن است به رفع تهوع و استفراغ کمک کند.
• پیادهروی، یوگا، تمرینهای تنفسی و مراقبه برای رفع خستگی و افزایش انرژی میتواند مفید باشد.
• روزهایی که انرژی و روحیه خوبی ندارید، یک هدف کوچک برای آن روز تعیین کنید. پیادهروی کنید، با یک دوست صحبت کنید یا یک دوش آرامبخش بگیرید.
داشتن اطلاعات درست میتواند کنترل و درک بیشتری را درباره بیماری به شخص بیمار بدهد. جستجو کردن تا جای ممکن در مورد بیماری و مشاوره با پزشک برای چگونگی هدایت یک سبک زندگی سالم میتواند به تصمیمگیری در مورد درمان و مراقبت کمک چشمگیری کند.
منبع: webmd













